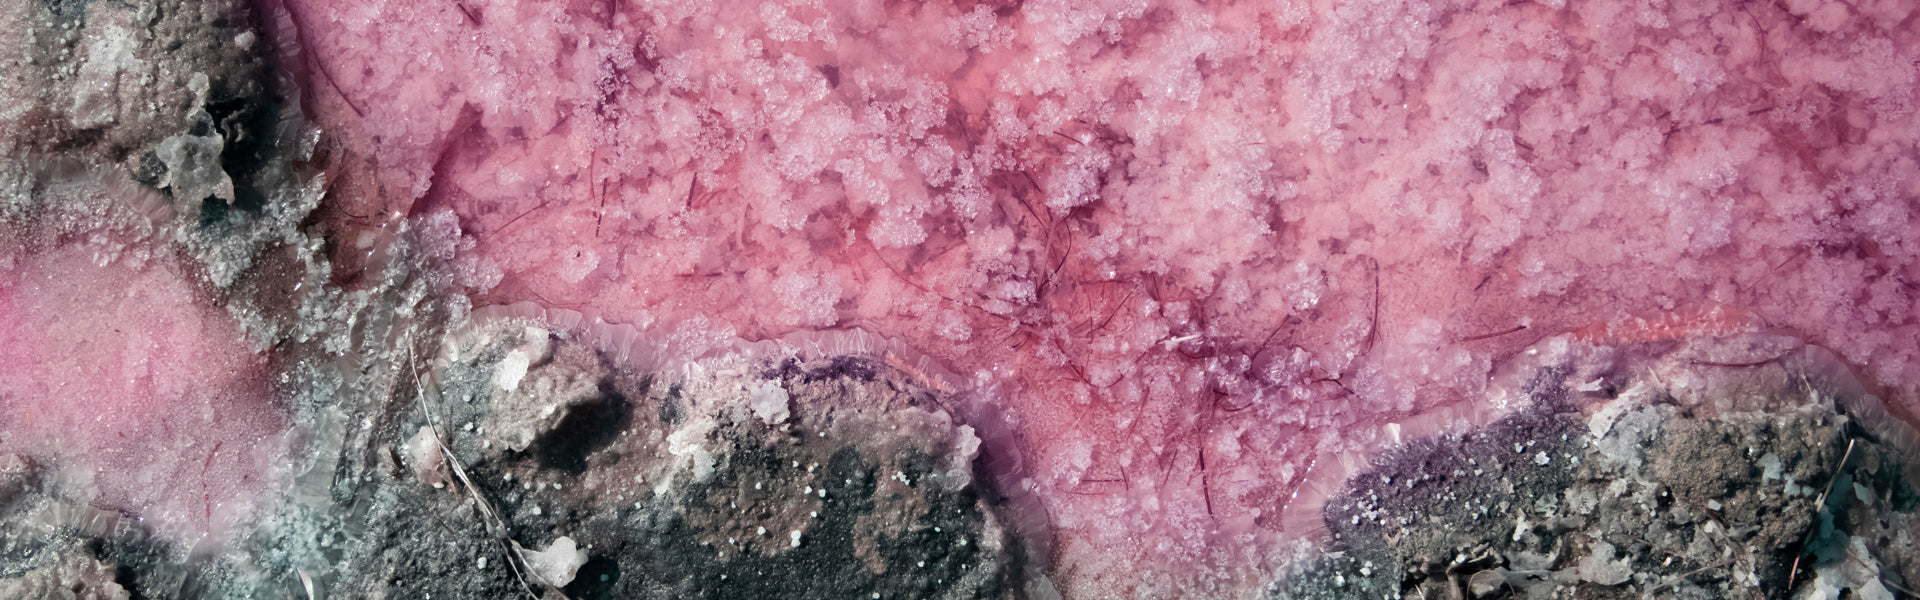

Dunaliella salina
Une algue naturellement riche en caroténoïdes
Dunaliella Salina : qu’est-ce que c’est ?
La Dunaliella salina est une micro-algue d’une jolie couleur rouge orangé. Elle se développe dans des environnements très salés tels que les lagunes, les salines ou les lacs salés (en Australie principalement). Cette algue est l’une des seules à pouvoir tolérer une si forte concentration de sel.
Dans des eaux peu profondes et exposées à une forte lumière, cette algue va protéger sa chlorophylle grâce aux pigments rouges qu’elle contient, notamment le bêta-carotène et la lutéine. Ces pigments la protègent de l’oxydation causée par les rayons UV, et sont très prisés en phytothérapie pour favoriser le bronzage.
Les bienfaits de la Dunaliella Salina
Connue pour sa richesse en bêta-carotène, cette algue à la couleur atypique possède de nombreuses propriétés. Elle est surtout utilisée pour préparer la peau au soleil : elle contient des caroténoïdes (principalement le bêta-carotène et la lutéine), qui sont des précurseurs de la vitamine A. Ils permettent en effet d’activer la mélanogénèse, c’est-à-dire la production de la mélanine par la peau.
La Dunaliella salina est donc idéale pour avoir bonne mine naturellement, tout en renforçant la peau face aux rayons UV. Elle est par exemple recommandée avant des expositions au soleil.
Cette algue possède également une forte activité antioxydante. Grâce à sa combinaison de 4 pigments antioxydants (le bêta-carotène, la zéaxanthine, la lutéine et l’astaxanthine) elle agit en synergie sur l’ensemble du corps, et notamment la vue. Du côté de la nutrition, la Dunaliella salina est aussi intéressante. Elle apporte une bonne source d’oméga-3 et 6, ainsi que des acides gras poly-insaturés, bénéfiques pour le système cardiovasculaire et le système nerveux.
Comment utiliser l’algue Dunaliella Salina ?
Cette algue se trouve essentiellement sous forme de compléments alimentaires. Elle est principalement utilisée pour accélérer le bronzage et protéger l’épiderme. Dans ce cas-là, elle est souvent associée à d’autres actifs riches en caroténoïdes et en vitamines C et E.
Elle se trouve soit en gélules, soit en capsules. Il est souvent conseillé de prendre entre une et deux gélules par jour, au moment des repas.
105 avis
Solaire bio - accélérateur bronzage
complément alimentaire

- Bêta-carotène naturel
- Préparation de la peau au soleil
- Effet antioxydant












